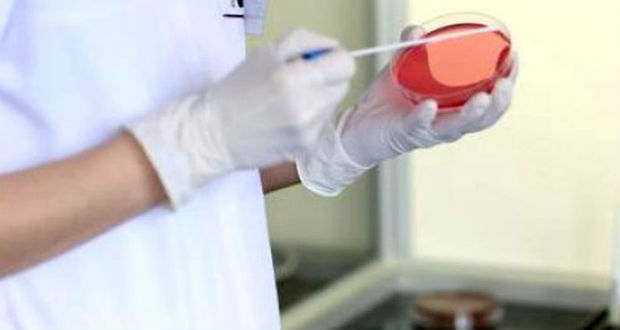
Közelíti a járványküszöböt az akut légúti vírusfertőzések száma

Mikulás-napi folkkocsma Beregszászban
A Hagyományok Háza Hálózat kárpátaljai kirendeltsége és a Sodró együttes szervezett folkkocsmát a II. Rákóczi Ferenc Kárpátaljai Magyar Főiskolán december 6-án. A repertoárban viski, szatmári és szilágysági rendek szerepeltek. A táncház meghívottjai ezúttal Rozsályi Dániel és Lakatos Fanni, a debreceni Hortobágy Néptáncegyüttes koreográfusai voltak. Az eseménynek egy nem mindennapi vendége is volt, ugyanis maga a…